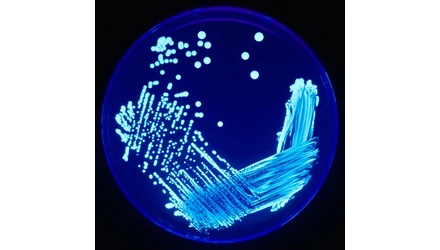
Vízhálózatok, intézmények Legionella mentesítése

A légiós betegség, más néven legionella-fertőzés, egy olyan megbetegedés, amelyet a Legionella nevű baktériumok okoznak. Ezek a baktériumok a környezetben is jelen lehetnek, de csak akkor jelentenek veszélyt, ha belélegzett vízcseppek formájában kerülnek a tüdőbe.
-
Kórokozók: A légiós betegség kórokozói a Legionella baktériumok, különösen a Legionella pneumophila 1-7 szerocsoportba tartozók. Ezek a baktériumok a szabad vizekben élnek, és terjedésüket a légkondicionáló berendezések is segítik. Nem megfelelően kezelt jakuzzi vize is fertőzött lehet.
-
Tünetek: A légiós betegség tünetei közé tartozik a fejfájás, köhögés, nehézlégzés, láz, magas láz, hasmenés, tüdőgyulladás és a Pontiac-láz.
-
Diagnózis: A betegség diagnózisát fizikális vizsgálat, kikérdezés és röntgen segíti. A vizelet Legionella-antigén kimutatására szolgáló gyorsteszt is fontos a korai diagnózis felállításában.
-
Megelőzés: A megfelelő higiénia, a légkondicionálók rendszeres karbantartása és a jakuzzik vízkezelése hozzájárulhat a fertőzés megelőzéséhez.
Fontos megjegyezni, hogy a légiós betegség súlyos lehet, különösen az idősebbek és a gyengébb immunrendszerű emberek számára.